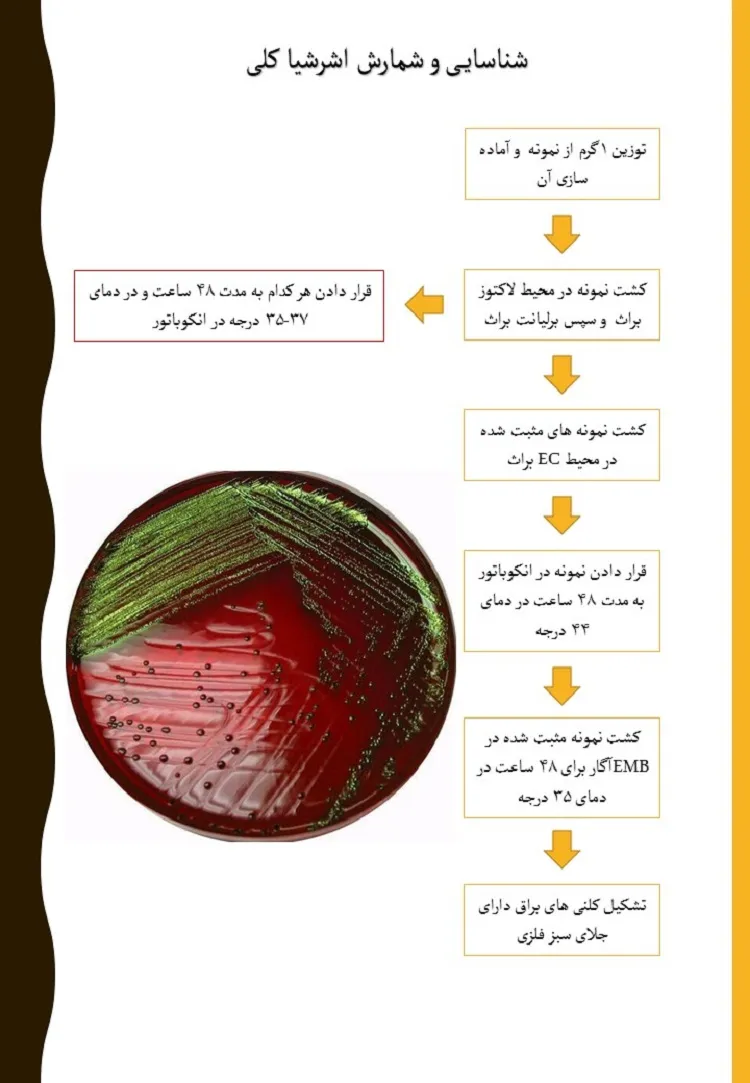

امروز 16 تیر 1405
نمونه پوستر آموزشی میکروبی
نمونه پوستر آموزشی میکروبی
پوستر آموزشیه که برای آموزش شناسایی میکروارگانیسم ها طی شده و به صورت یک سری آموزشی هست.
25 شهریور 1398
مهارتهای استفاده شده
25 شهریور 1398